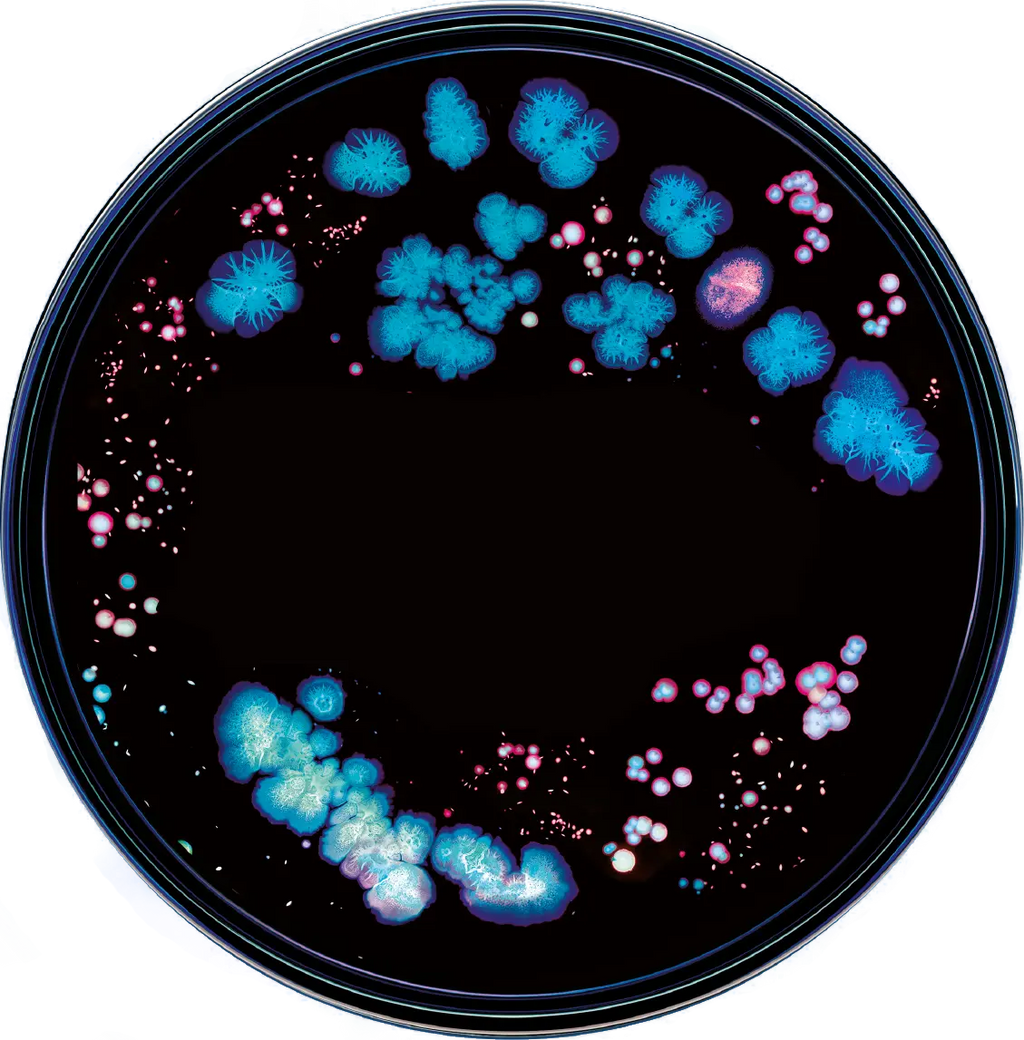

FSA/HSA Eligible. Free Shipping, Always.

Diet + Nutrition
Gut-Brain Axis
IBS
Longevity
microbiome
Mood
10 Reasons To Test Your Gut Microbiome
Discover what gut microbiome testing is and why it's useful for evaluating your health risks